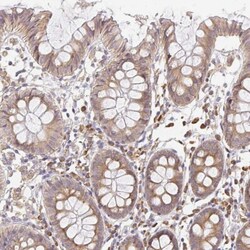
SLC35B3 Antibody, Novus Biologicals 25 &mu;L, Unlabeled:Antibodies, Polyclonal

missing translation for 'onlineSavingsMsg'
Learn More
Learn More
SLC35B3 Antibody, Novus Biologicals™
Rabbit Polyclonal Antibody
Brand: Novus Biologicals NBP2-37965-25ul
Dieser Artikel kann nicht zurückgegeben werden.
Rückgaberichtlinie anzeigen
Beschreibung
SLC35B3 Polyclonal specifically detects SLC35B3 in Human samples. It is validated for Immunohistochemistry, Immunohistochemistry-Paraffin.
Spezifikation
| SLC35B3 | |
| Polyclonal | |
| Immunohistochemistry, Immunohistochemistry-Paraffin 1:200 - 1:500 | |
| Q9H1N7 | |
| SLC35B3 | |
| This antibody was developed against a recombinant protein corresponding to amino acids: QQAKDIQNITVQETNKNNSESIECSKITMDLKFNNSRKYISITVPSKTQTMSPHIKSVDDVVVLGMNL | |
| 25 μL | |
| Primary | |
| Specificity of antibody verified on a Protein Array containing target protein plus 383 other non-specific proteins. | |
| Store at 4°C short term. Aliquot and store at-20°C long term. Avoid freeze/thaw cycles. |
| Immunohistochemistry, Immunohistochemistry (Paraffin) | |
| Unconjugated | |
| PBS (pH 7.2) and 40% Glycerol with 0.02% Sodium Azide | |
| 3' phosphoadenosine 5' phosphosulfate transporter 2, adenosine 3'-phospho 5'-phosphosulfate transporter 2, C6orf196, CGI-19, chromosome 6 open reading frame 196, PAPS transporter 2, PAPST2dJ453H5.1,3'-phosphoadenosine 5'-phosphosulfate transporter, Solute carrier family 35 member B3, solute carrier family 35, member B3 | |
| Rabbit | |
| Affinity Purified | |
| RUO | |
| 51000 | |
| Human | |
| IgG |
Berichtigung von Produktinhalten
Bitte geben Sie uns Ihr Feedback zu den Produktinhalten, indem Sie das folgende Formular ausfüllen.
Name des Produkts
Haben Sie Verbesserungsvorschläge?Übermitteln Sie eine inhaltliche Korrektur